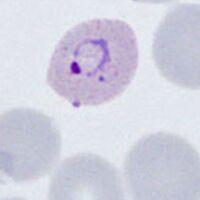

Plasmodium vivax: Morphology
From haematologyetc.co.uk
Navigation
(click blue highlighted text to return to page)
Malaria main index
>Species identification: summary page
>>This page: P.vivax: morphology
| The early trophozoite |
The earliest ring forms may be indistinguishable from other species, but during this stage the parasite tends to aquire a more irregular forms and to show signs of modification of the erythrocyte (added dots, and altered size and shape).
- erythrocytes begin to show increased size and altered shape
- parasites retain a ring form but may aquire a more irregular form
- parasites are generally large - occupying up to half of the erythrocyte
- cytoplasmic Schüffner's dots may appear at this stage, although pigment is less uncommon
| The late trophozoite |
The later growth stage during which parasites grow considerably and lose their ring appearance, this process is accompanied by substantial modification of the red cell and metabolism of it's haemoglobin to form malaria pigment.
- infected erythrocytes become significantly enlarged and irregular in shape
- parasites lose their ring appearnace becoming irregular and "amoeboid" in form
- numerous red/purple Schüffner's dots are predent in the cytoplasm of red cells
- malaria pigment is often present and has an irregular distribution
| The schizont |
The asexual stage of malaria parasite development - only some trophozoites form schizonts, but those that do undergo successive cycles of replication within the red cell to generate multiple "merozoites" that then each invade a new red cell to continue and increase the infection.
- a range of maturing schizonts will generally be present within enlarged red cells
- when mature schizonts may contain 16-24 separate merozoites
- Schüffner's dots can be detected in any residual cytoplasm of the erythrocyte
- malaria pigment is visible in irregularly distributed clumps over the schizont surface
The gametocyte
| The gametocyte |
The sexual replication form (very distinctive).
- red cells are very large and have ovoid or distorted forms
- macrogametocytes (female form) will often entirely fill the erythrocyte
- microgametocytes (male form) have a cytoplasmic rim with visible Schüffner's dots
- malaria pigment is clumped evenly over the surface of the gametocyte